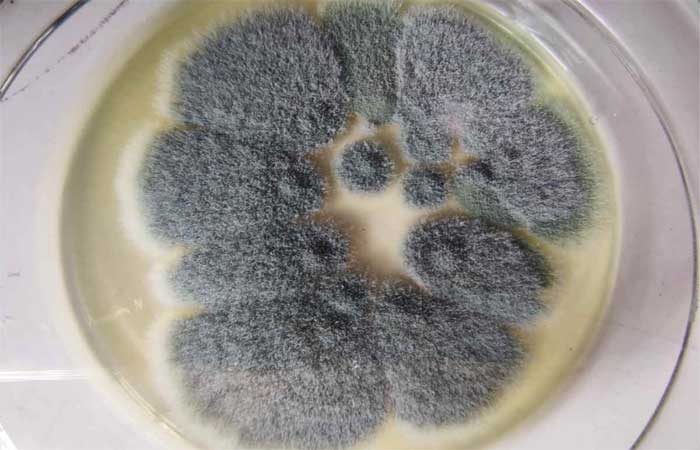
Esses fungicidas químicos modificaram o mofo comum que agora pode infectar você e até se tornar letal

As infecções fúngicas afetam mais de um bilhão de pessoas em todo o mundo, com uma taxa de mortalidade que se equipara à da malária ou da tuberculose – uma verdadeira epidemia que ainda não se fala o suficiente.
Entre os fungos mais nocivos para a saúde humana está certamente o Aspergillus fumigatus, um mofo ambiental disseminado em todas as regiões do mundo, que pode causar o aparecimento de inúmeras doenças pulmonares – como a aspergilose invasiva (AI), doença que atinge severamente as vias aéreas causando asma, pneumonia, sinusite, podendo evoluir para necrose hemorrágica ou infarto.
A IA afeta 10-20 milhões de pessoas em todo o mundo e, se para aqueles que não sofrem de doenças particulares o curso ocorre sem consequências, em pacientes frágeis (por exemplo, aqueles que foram submetidos a transplante de órgão ou células-tronco) e já experimentados por outras patologias como neutropenia, fibrose cística e, em última análise, Covid-19 podem piorar até a morte.
Infelizmente, estudos recentes mostraram que esse mofo em particular é capaz de resistir aos antifúngicos azólicos, uma vez eficazes na erradicação de Aspergillus fumigatus , tanto no tratamento clínico quanto na desinfestação ambiental. A resistência aos medicamentos ao azólico tem sérias implicações clínicas: em pacientes com IA, por exemplo, causa um aumento de 25% na mortalidade.
Uma equipe de pesquisadores do Imperial College London está observando a situação de perto. Os pesquisadores isolaram 218 amostras de Aspergillus fumigatus da Inglaterra, País de Gales, Escócia e Irlanda : sete em cada dez amostras (153 amostras) vieram de pessoas doentes, enquanto o restante (65) veio do meio ambiente – solo, composto, plantas, ar. .
De todas as amostras analisadas, 106 se mostraram resistentes a pelo menos um dos fármacos azólicos usualmente utilizados no tratamento médico: em especial, 48% das amostras se mostraram resistentes ao itraconazol, 29% ao voriconazol e 21% ao posaconazol. ; além disso, mais de 10% das amostras demonstraram resistência a dois ou mais fármacos azólicos.
Mas por que o mofo se tornou imune à ação das drogas?
A resposta é muito simples: o uso generalizado de fungicidas azólicos para uso agrícola e a exposição a eles pela população tornou o fungo resistente à droga.
Compreender os hotspots ambientais e a base genética da evolução da resistência aos medicamentos fúngicos requer atenção urgente, porque a resistência está comprometendo nossa capacidade de prevenir e tratar essa doença, explica Matthew Fisher , autor do estudo. – A prevalência de aspergilose resistente a medicamentos aumentou de níveis insignificantes antes de 1999 para 3-40% dos casos atuais em toda a Europa.
Ao mesmo tempo, mais e mais pessoas podem ser suscetíveis à infecção por Aspergillus fumigatus devido ao número crescente de pessoas que recebem transplantes de células-tronco ou órgãos sólidos, que estão em terapia imunossupressora ou que têm doença pulmonar ou infecções respiratórias virais graves.
Os cientistas já haviam soado o alarme (inédito)
A emergência de saúde ligada à resistência a antibióticos deste mofo em particular não é nova, infelizmente , e vários estudos já mostraram os perigos para ecossistemas e animais associados à exposição a medicamentos fungicidas azólicos.
Em particular, um estudo realizado pela União Européia mostrou como a exposição ao fungicida em ecossistemas marinhos é responsável por alterações endócrinas em peixes e outros organismos aquáticos : estes, de fato, podem acumular azóis dentro do organismo e transformá-los. consequências como redução ou alteração do crescimento e até mesmo a morte.
Os danos ambientais significativos causados pela exposição aos fungicidas aumentam quando consideramos que muitos dos rios e córregos contaminados fornecem água potável para as comunidades humanas. Em suma, o alarme levantado pelos cientistas é muito claro: tanto os ecossistemas aquáticos quanto os humanos (através do consumo de água potável) correm concretamente o risco de contaminação por azóis antifúngicos.
No entanto, esses fungicidas ainda não são proibidos por lei, e seu uso continua na agricultura em todo o mundo, com graves consequências que já estamos vivenciando.